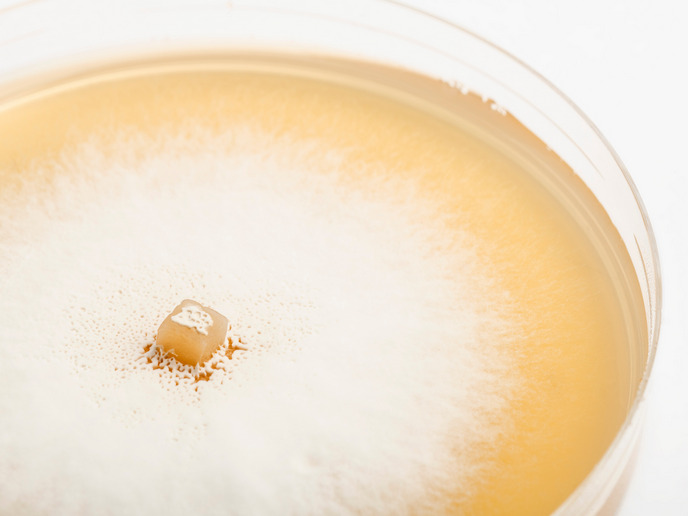

Bringing materials made from mycelium fibres to market
Modern consumers are looking for socially responsible products that reduce damage to the environment by adhering to the principles of the circular economy. To meet this growing demand, the EU-funded MY-FI(opens in new window) project brought together a consortium of scientists, manufacturers and market specialists to produce high-quality next-gen material with low environmental cost.
Making the most of fungi
Most textiles used in contemporary clothing – such as cotton, linen and wool – are plant or animal-based. The resources used to produce these textiles are costly, and the processes for treating them can have negative impacts on the environment. As an alternative to these conventional materials, one grown with mycelium offers an attractive array of characteristics. Fungi grow in branching structures called hyphae, which are mainly composed of chitin(opens in new window), a polysaccharide. Chitin closely resembles cellulose, a polysaccharide frequently used in textiles. A versatile and adaptable material, chitin is non-toxic and biodegradable.
Innovative technologies and the circular economy
MY-FI employed two fermentation processes for growing mycelium. Dynamic liquid fermentation uses stirred tanks to grow the fibres. Following an alkaline process, a solid is removed, yielding a flexible and semitransparent material. Surface liquid fermentation begins with a substrate on which the fungi grow under specific conditions. Once the material has dried, what remains are soft white sheets of pure mycelium. Growing mycelium fibres in this way presents many ecological advantages. The fermentation processes can use different side-streams from the agro-food industry or even other industries, such as textile residues and spent grains from breweries, thus contributing to intersectoral circularity. Also, the fermentation processes produce minimal CO2 emissions and require limited energy. Since fermentation can be managed locally, nearshoring of production is feasible, reducing transportation costs and enabling shorter supply chains. Not only are mycelium products better for the environment, but they are better for people too. MY-FI prioritised safety in manufacturing materials, and the processes and products are non-toxic for producers as well as consumers. With these encouraging results, MY-FI sees market adaptation in the near future. According to project coordinator Annalisa Moro: “The Surface Liquid Fermentation process, developed by MOGU(opens in new window), is the most promising method established during the project. Its implementation at an industrial scale will be the focus of the coming years.”
Material characteristics and applications
Mycelium-based next-gen materials are smooth, durable and high-performing. They make an ideal alternative to leather in high-end fashion products, such as wallets, belts, handbags, footwear and accessories. The nature of the material also lends itself well to certain automotive features, like cushions, headrests and steering wheels. In the final stage of the project, MY-FI achieved prototypes of four nonwoven textiles made from mycelium fibres. Moro shares: “Project partners were able to manufacture various prototypes for the fashion and automotive industries, including bags, two dresses, a skirt, a bodysuit, a jacket, various wallets, as well as two headrests and a dashboard fascia for cars.” Such applications of next-gen material made from mycelium are just the beginning. As these materials enter the market, other sectors will find new applications for them. The work of MY-FI is only the start of a green transformation in the fashion industry.